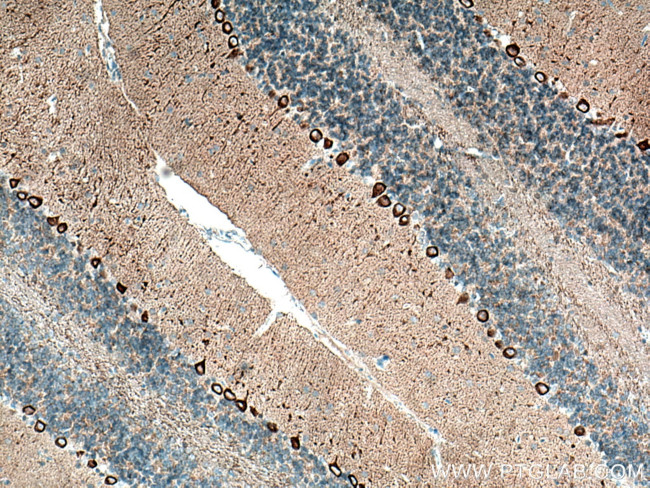
a-Synuclein Antibody in Immunohistochemistry (Paraffin) (IHC (P))

Search
Proteintech
a-Synuclein Monoclonal Antibody (1B10E9)
{{$productOrderCtrl.translations['antibody.pdp.commerceCard.promotion.promotions']}}
{{$productOrderCtrl.translations['antibody.pdp.commerceCard.promotion.viewpromo']}}
{{$productOrderCtrl.translations['antibody.pdp.commerceCard.promotion.promocode']}}: {{promo.promoCode}} {{promo.promoTitle}} {{promo.promoDescription}}. {{$productOrderCtrl.translations['antibody.pdp.commerceCard.promotion.learnmore']}}
产品信息
66412-1-IG
种属反应
宿主/亚型
分类
类型
克隆号
抗原
偶联物
形式
浓度
规格
纯化类型
保存液
内含物
保存条件
运输条件
产品详细信息
This antibody can recognize all isoforms of alpha-syn.
Immunogen sequence: MDVFMKGLS KAKEGVVAAA EKTKQGVAEA AGKTKEGVLY VGSKTKEGVV HGVATVAEKT KEQVTNVGGA VVTGVTAVAQ KTVEGAGSIA AATGFVKKDQ LGKNEEGAPQ EGILEDMPVD PDNEAYEMPS EEGYQDYEPE A (1-140 aa encoded by BC013293)
靶标信息
Alpha-synuclein is a member of the synuclein family, which also includes beta- and gamma-synuclein. These proteins are abundant in the brain and play a role in regulating synaptic transmission and membrane trafficking. Alpha- and beta-synuclein have been shown to selectively inhibit phospholipase D2, suggesting that they may also be involved in signaling pathways. Defects in the SNCA gene, which encodes alpha-synuclein, have been implicated in the pathogenesis of Parkinson's disease. Additionally, alpha-synuclein peptides are a major component of amyloid plaques in the brains of patients with Alzheimer's disease. Multiple alternatively spliced transcripts encoding different isoforms have been identified for this gene. Diseases associated with SNCA include Parkinson Disease 1, Autosomal Dominant and Dementia, Lewy Body.
仅用于科研。不用于诊断过程。未经明确授权不得转售。
生物信息学
蛋白别名: 41 synuclein; Alpha synuclein; Alpha-synuclein; I+/--synuclein; NACP; non A-beta component of AD amyloid; Non-A beta component of AD amyloid; non-A4 component of amyloid; Non-A4 component of amyloid precursor; SNCA; synuclein alpha-140; synuclein, alpha (non A4 component of amyloid precursor); unnamed protein product
基因别名: alphaSYN; NACP; PARK1; PARK4; PD1; SNCA; Syn
UniProt ID: (Human) P37840, (Rat) P37377, (Mouse) O55042
Entrez Gene ID: (Human) 6622, (Rat) 29219, (Mouse) 20617